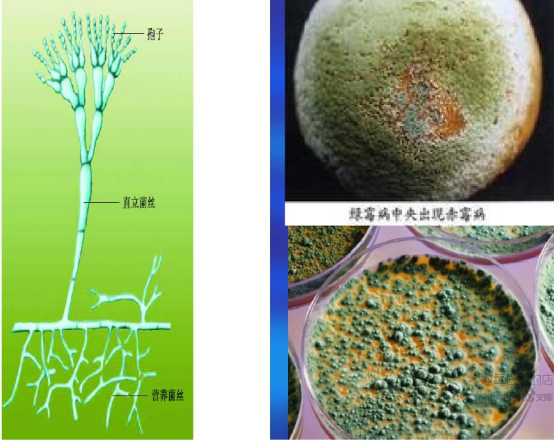

食品生产车间常见霉菌有哪些?污染来源及防治措施呢?
食品加工过程中,“微污染源”有很多,如何防止食品被污染是一项重要课题。霉菌作为微污染源中的一种,如果不加以控制,势必会影响到食品保质期的长短。
那么,应该如何控制霉菌污染食品呢?
沃特食品检测专家认为:控制霉菌污染,首先要了解霉菌的生长环境、污染食品的条件。在此基础上,方可以提出合理的防控措施,提高食品卫生质量。

一、常见的霉菌有哪些呢?
1、曲霉
在自然界中分布广泛, 它以土壤或空气为媒介, 可引起食物、谷物和果蔬的霉腐变质,有的可产生致癌性的黄曲霉毒素。该霉在原料贮藏期间几乎不会死亡。因其对干燥抗性强, 故常在一些干燥食品中被分离出来, 而糖类和壳类处理工厂,也常被此类霉菌污染。烘焙产品中也常因原料,如糖、花生、油、大米等原料带入曲霉污染。

2、青霉
与曲霉一样在自然界中广泛分布, 而且具同样的生态, 但曲霉生长于中温至高温, 而青霉以中温性为主, 代表种是灰绿青霉,从土壤或空气中很易分离。青霉的孢子耐热性较强,菌体繁殖温度较低,酒石酸、苹果酸、柠檬酸等烘焙产品常用的酸味剂又是它喜爱的碳源,因而常常引起这些制品的霉变,是干燥性壳物产品处理工厂的主要霉菌。其有害性是造成水果、蔬菜、肉食及衣履腐败和产生霉菌毒素以及诱发过敏。
3、毛霉
毛霉菌又叫黑霉、长毛霉。毛霉在土壤、粪便、禾草及空气等环境中存在。在高温、高湿度以及通风不良的条件下生长良好。在工厂湿度高的环境、通风不良的环境与气温差异显著的地方(如湿的地板和天花板) , 常有此霉菌存在。

4、根霉
黑根霉也称匐枝根霉,分布广泛,常出现于生霉的食品上,瓜果蔬菜等在运输和贮藏中的腐烂及甘薯的软腐都与其有关。黑根霉是目前发酵工业上常使用的微生物菌种,能糖化淀粉、转化蔗糖 ,产生乳酸、反丁烯二酸及微量酒精。黑根霉的最适生长温度约为2~8℃,超过32℃不再生长。

5、交链孢霉
交链孢霉属中温性和好湿性霉菌,易造成腐朽、腐败和过敏。在高湿度的工厂环境(如糕点、鱼肉、水产加工与肉食加工环境) 的天花板、墙与地板、配水管的黑色霉菌, 几乎为该菌或枝孢霉。

6、镰刀菌
镰刀菌是一类世界性分布的真菌,它不仅可以在土壤中越冬越夏,还可侵染多种植物(粮食作物、 经济作物、药用植物及观赏植物),引起植物的根腐、茎腐、茎基腐、花腐和穗腐等多种病害,寄主植物达100余种。本可产生镰刀菌毒素,食用霉变的粮食可导致人患病和死亡,某些菌种可诱发人皮肤和角膜溃疡,恶性肿瘤的发生可能与有的菌种有关。

二、霉菌一般需要怎样的繁殖条件呢?
与霉菌的生长繁殖关系密切的有水分、温度、基质、通风等条件,为此,只有充分的了解霉菌的生长习性,才能为下一步控制霉菌提供理论依据。
(1) 水分
霉菌生长繁殖首要条件是必须保持一定的水分,大部分霉菌于相对湿度90 %以上, 水含量18 %的高湿度环境下以上容易生长。当食品中的水分活度为0.98时,霉菌最易生长繁殖,当水分活度在0.7以下时,霉菌的繁殖才受到真正的抑制,阻止产毒。所以,水分越高的产品,虽口感会更好,但伴随着长霉的风险也会更高。
(2) 温度
温度对霉菌的繁殖及产毒均有重要的影响,不同种类的霉菌其最适温度是不一样的,大多数霉菌繁殖最适宜的温度为25~30℃,在0℃以下或30℃以上,不能产毒或产毒力减弱。就如黄曲霉的最低繁殖温度范围是6-8℃,最高繁殖温度是44~46℃,最适生长温度37℃左右,但产毒温度则不一样,略低于生长最适温度,其最适产毒温度为28-32℃。
(3) 营养基质
与其它微生物生长繁殖的条件一样,不同的食品基质霉菌生长的情况是不同的,一般而言,营养丰富的食品(如以碳水化合物为主要成分的植物性食品原料)其霉菌生长的可能性就大,天然基质比人工培养基产毒为好。
(4) 氧
霉菌为绝对好气性微生物, 于通气良好环境下生长较好, 故厌氧下其生长可被抑制。
三、霉菌污染的来源
不同的食品厂由于加工产品不同, 故污染的霉菌种类也有所差异,但面包、糕点加工厂的霉菌污染源一般来自水、通风良否、操作人员、机械设备、食品原料和包材等。
(1) 面包、糕点加工过程中常产生大量水汽,易造成墙壁潮湿及冷凝水形成的情况 , 容易滋生霉菌。
(2) 一些水槽、水桶、水管、自来水的水龙头、自来水管、地板与底板等水环境,由于长期贮水,所以污染情形特别常见。如,车间地面、明沟、气帽有积水潮湿;冷凝水的管路、墙壁、天花板、空调口等;生产过程产生的液体废弃物未及时清理出车间;离墙离地近的设备表面、潮湿墙面、冷风机容易产生冷凝水滋生霉菌。
(3) 空气中浮游霉菌的二次污染,如空气中滋生的霉菌、人员走动时地面扬尘中含有的细菌、空调或新风管道中吹出的霉菌等。
(4) 操作人员自身的二次污染,如手部消毒不彻底、不洁净衣物手套接触食品,违反卫生管理制度及不良的卫生习惯,如随意串岗、不按规定佩戴口罩遮住鼻子、包装间没按规定穿连体衣、对着产品说话、打喷嚏、经常抓耳挠腮等等。
(5) 设备、容器的交叉感染,如设备、容器清洗消毒不彻底、不按规定流程定期清洗等、消毒液选用不当或使用剂量不够等。
(6) 原料带入的二次污染,可能由于本身质量不过关或者在储存条件不当受到霉菌污染。
(7) 通过包材的污染,如包装材料密封性不好,外包装或包装袋表面不清洁,附着有微生物,若杀菌不彻底,则其残留的霉菌素则会直接污染食品。
四、霉菌污染的防治措施
1、控制车间温湿度
对生产车间霉菌有效控制,首先必须控制车间的温度和湿度,常开抽湿机及空调,尤其是潮湿天气,建议车间温度在24度以下,湿度控制在55%以下,确保车间干爽,因为过高的温湿度会促进霉菌的生长。同时应设有效的换气设施,保证车间抽湿机的正常运转,保证车间内部空气能够达到要求指标,空调的换气程度好坏直接影响到霉菌的产生。如果车间能保证及时将含有大量水份的空气排出车间,以防止室内温度过高、蒸汽凝结或异味等发生,大大缩小了可能存在霉菌的可能性。
2、对车间进行空气消毒
一个细菌及霉菌在24小时内会繁殖成百上千甚至上百万,包装间可配上臭氧消毒机、紫外灯(装在包装机上方)等。晚上工人下班后,每日车间的空气杀菌可采用臭氧消毒机和紫外线等同时进行,防止空气中滋生的微生物累加到白天造成对产品不利,当然,要记得下班后打开, 第二天上班前关闭,消毒期间人员必须撤离哦。在潮湿天气,建议包装间每隔2周用甲醛进行彻底的熏蒸消毒。(具体做法可咨询广州拜晴技术部)
3、班前、班后工器具注意消毒
酒精喷雾消毒是制造食品时防止霉菌与细菌污染常用的方法, 每天班前、班后对车间内部墙壁、风机、下水道、案面、手部、围裙套袖、预冷库和库门、速冻库门、包装室、工器具消毒间使用75%的酒精喷洒消毒,班中每2小时对风机、墙壁、下水道实施75%的酒精喷洒,杀灭霉菌。
4、控制车间内卫生,避免死角位
首先要保持生产车间的内部工具的清洁和卫生,注意对一些卫生死角进行严格的卫生清理和保持。每天下班后清洗干净工器具、设备等,每半月实施一次深度清洁。即管理者与操作人员应具有卫生观念, 随时注意操作的卫生与减少 污染的可能性 , 必须从加强员工卫生教育着手。比如,操作案面的背面,天花板、墙壁、空调、制冷风机、抽湿机、干手机等的卫生清理,清理完卫生后所有的墙壁、天棚、设备、器具、案面表面要用酒精擦两遍以上。请特别注意清理制冷风机的散热片和冷气的出风口以及内部电机叶片,这是一个很容易忽视的角落。
5、保证操作人员的清洁卫生
人员的工作服、更衣室等,必须保持卫生清洁,定期清洗和进行紫外线或臭氧杀菌30分钟以上,防止人为造成霉菌的交叉污染(不可在有人情况下杀菌)。工人每次进入车间前(尤其是冷却包装间),先用洗手液洗手,然后换工作服、戴袖套、围裙、帽子、口罩,然后双手泡入消毒液(二氧化氯溶液或在超市买家庭用的消毒液稀释)中5秒,然后直接甩干或用干手机烘干。注意:在消毒液中泡后就不要用布擦干。
6、杜绝车间的污染源,设置洁净室
在食品工厂内的加热后放冷至包装阶段,为最需防止外部浮游菌侵入和落菌的污染,有条件者可以设置洁净室,利用空气导入设施,将可达到空气洁净化, 减少污染的目的。同时,请注意以下细节:对于制造环境的天花板、壁面与地板等, 为防止霉菌污染,车间的一切用具包括装修所用的材料尽量使用塑料、不锈钢等易清洗、防腐蚀、抗霉菌与防止结露的材料,尽量避免使用木头、铁等材料,因为木头遇水湿润后易长霉点,铁材质易生锈脱落影响产品质量。另外,冷却包装间内不得存放纸皮、木头、脏毛巾、窗帘扫把、拖把等容易藏污纳垢的物品,原料外包装物应拆除后再传送进冷却间,以避免污染产品。